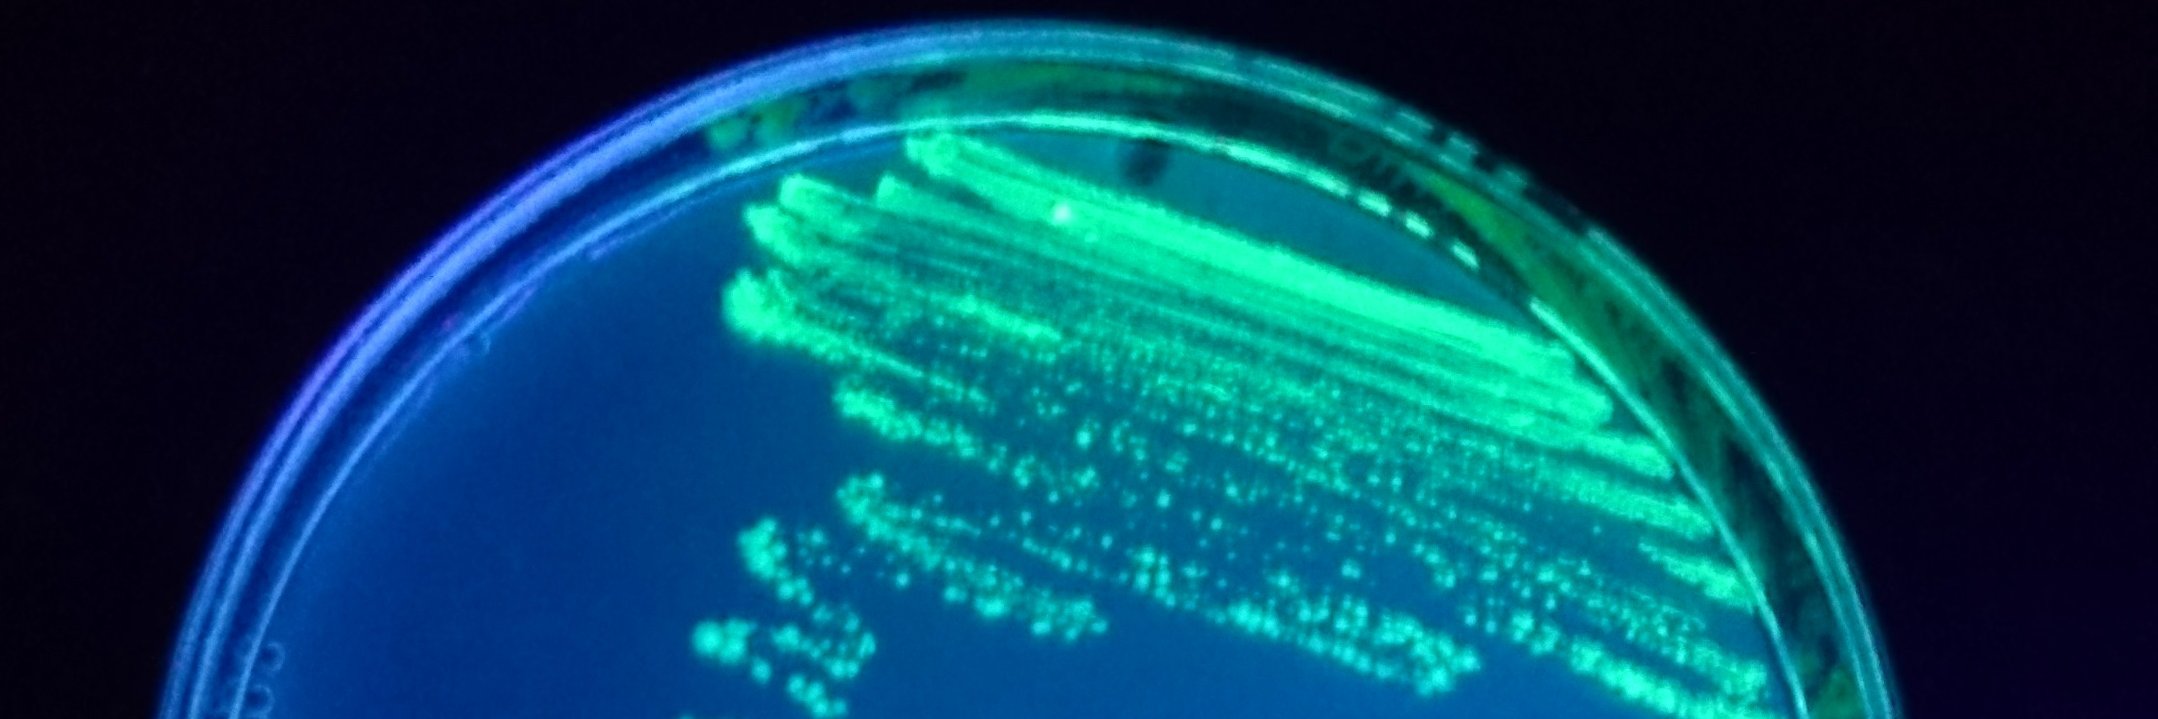
Adán Ramírez Rojas banner

Adán Ramírez Rojas
216 posts

Congratulations @adanramirezro for finishing your #PhD! It has been a journey. First PhD of the lab #proudPI. Funny enough we dressed inversely. Thanks to the evaluation committee, colleagues and team who made the event unforgettable. Adán even turned into a Macropore sequencer.



New preprint from our lab & another chapter in the PhD thesis of @MaikSchauerte 🥳! We describe #phage-encoded NAD-capped #RNA & analyse biosynthesis & decapping pathways during the infection of E. coli & T4! Great collaboration with @DSchindler_PDR Stefanie Kaiser @mpi_marburg



Paper Alert 🚀! Exciting findings from @RebeleinLab! Two proteins are crucial for electron supply of Fe #Nitrogenase: new targets for improving #biocatalysis in #sustainable #fertilizer and carbon compound synthesis. Check out our press article: mpi-marburg.mpg.de/1361203/2024-0…














